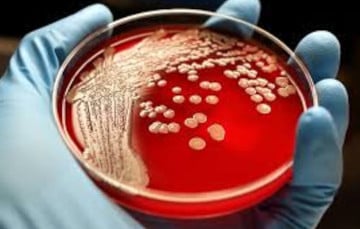
В Беларуси скрывают более 300 очагов смертельно опасной болезни

В Беларуси скрывают более 300 очагов смертельно опасной болезни
1- 28.02.2026, 10:56
- 7,588
Опубликовано содержание засекреченного документа.
В распоряжении «Зеркала» оказался план профилактики сибирской язвы на 2024–2025 годы. По данным Министерства сельского хозяйства на начало 2023 года, в нашей стране — 589 потенциально опасных мест, где в разные годы находили бактерию Bacillus anthracis, которая вызывает это заболевание. На таких территориях есть риск заражения, потому что споры этой бактерии могут выживать даже в самых неблагоприятных условиях и сохранять жизнеспособность в почве до 100 лет. Инфекционисты США и вовсе называют Bacillus anthracis оружием биотерроризма.
В своем документе Минсельхозпрод подчеркивает, что официально зарегистрировано 307 почвенных очагов сибирской язвы.
— На остальных стационарно неблагополучных пунктах конкретные места захоронения больных животных не установлены, — говорится в документе, но карты с этими пунктами в документе нет.
Из-за того, что в 282 очагах точные места захоронения больных животных неизвестны, растут риски распространения сибирской язвы. Люди могут использовать зараженные земли для сельского хозяйства, строительства и так далее.
Министерство предупреждает, что последний случай заболевания среди людей регистрировали в 1995 году. А среди животных — в августе 2019 года. Тогда сибирскую язву выявили у лошади в Столинском районе.
— Удалось не допустить дальнейшего распространения заболевания среди животных и предотвратить возникновение случаев заболевания среди населения, — пишет министерство.
Когда сибирская язва смертельно опасна?
Споры Bacillus anthracis обычно находятся в почве. Как правило, ими заражаются животные — чаще всего коровы, лошади, козы. Обычно — через траву с частичками почвы и пыли, где и содержатся бактерии, реже — когда их кусают комары или пыль со спорами попадает в раны или порезы на коже. Животные заболевают быстро, и если они не привиты, то сибирская язва для них практически в 100% имеет летальный исход.
От контакта с животными чаще всего заражаются и люди. Обычно это происходит, когда споры попадают на слизистую или в порезы на коже, а также при употреблении зараженного мяса (риски заболеть через молоко гораздо ниже). Реже заразиться можно при вдыхании пыли со спорами или от укуса комаров.
Кожная форма сибирской язвы — самая распространенная. Симптомы появляются через два-три дня после заражения (но в целом инкубационный период может варьироваться от двух часов до 14 дней). Сначала человек чувствует зуд, затем на коже появляется пузырек, а потом он превращается в язву. При своевременном лечении смертность от нее не превышает 2–3%.
Однако наиболее опасные формы — легочная и кишечная. Здесь вероятность умереть намного выше. Так, при легочной форме сибирской язвы первые признаки похожи на грипп. Через 3–5 дней развивается острая легочная недостаточность, которая приводит к шоку и летальному исходу в 100% случаев, если пациента не лечить, и до 55% случаев даже при оказании помощи.
При кишечной форме у людей повышается температура, сильно болит живот, есть рвота и жидкий стул с кровью. Летальность в таком случае составляет 25−65%.
Почему в США считают сибирскую язву возможным биологическим оружием?
В 2001 году неизвестные разослали по США письма с порошкообразными спорами бактерии Bacillus anthracis. Это привело к 22 случаям заражения (12 из заболевших были почтальонами). В итоге умерли пять человек.
— На протяжении почти столетия в ряде стран активно действуют программы по созданию биологического оружия на основе сибирской язвы. Мы не знаем, произойдет ли еще одна атака с применением сибирской язвы и когда это может случиться, — предупреждают на своем сайте Центры по контролю и профилактике заболеваний США (CDC).
Также ведомство отнесло бактерию Bacillus anthracis к биологическим агентам первого уровня опасности и разработало рекомендации, как обезопасить себя в случае атаки.







